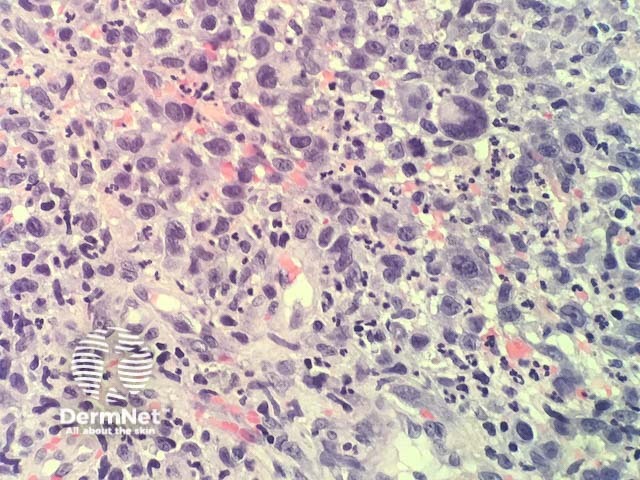
Figure 3

Main menu
Common skin conditions
NEWS
Join DermNet PRO
Read more
Quick links
Author: Adjunct A/Prof Patrick Emanuel, Dermatopathologist, Clinica Ricardo Palma, Lima, Peru. DermNet Editor-in-Chief: Adjunct A/Prof Amanda Oakley. Copy edited by Gus Mitchell. July 2018.
Introduction Histology Special studies Differential diagnoses
Pseudocarcinomatous hyperplasia can occasionally be observed in biopsies of CD30-positive lymphoproliferative disorders. It is important to be cognisant of this association, because epithelial hyperproliferation can overshadow large atypical lymphoid cells, leading to an erroneous diagnosis of squamous cell carcinoma or keratoacanthoma.
In pseudocarcinomatous hyperplasia in anaplastic large cell lymphoma, histopathology usually shows a cup-shaped keratinocytic proliferation with minimal cytologic atypia resembling a keratoacanthoma (figure 1). Directly adjacent to this proliferation, there is a dermal tumour composed of highly atypical large hematopoietic cells (figure 2,3).

Figure 1

Figure 2
Figure 3
Immunohistochemical studies reveal the dermal tumour is strongly positive with CD30. These cells show no positivity with p63 or CK5/6, which helps establish that these cells are not anaplastic squamous cell carcinoma cells. Melanoma markers are also negative in the dermal tumour cells.
Other diagnoses to be considered include: